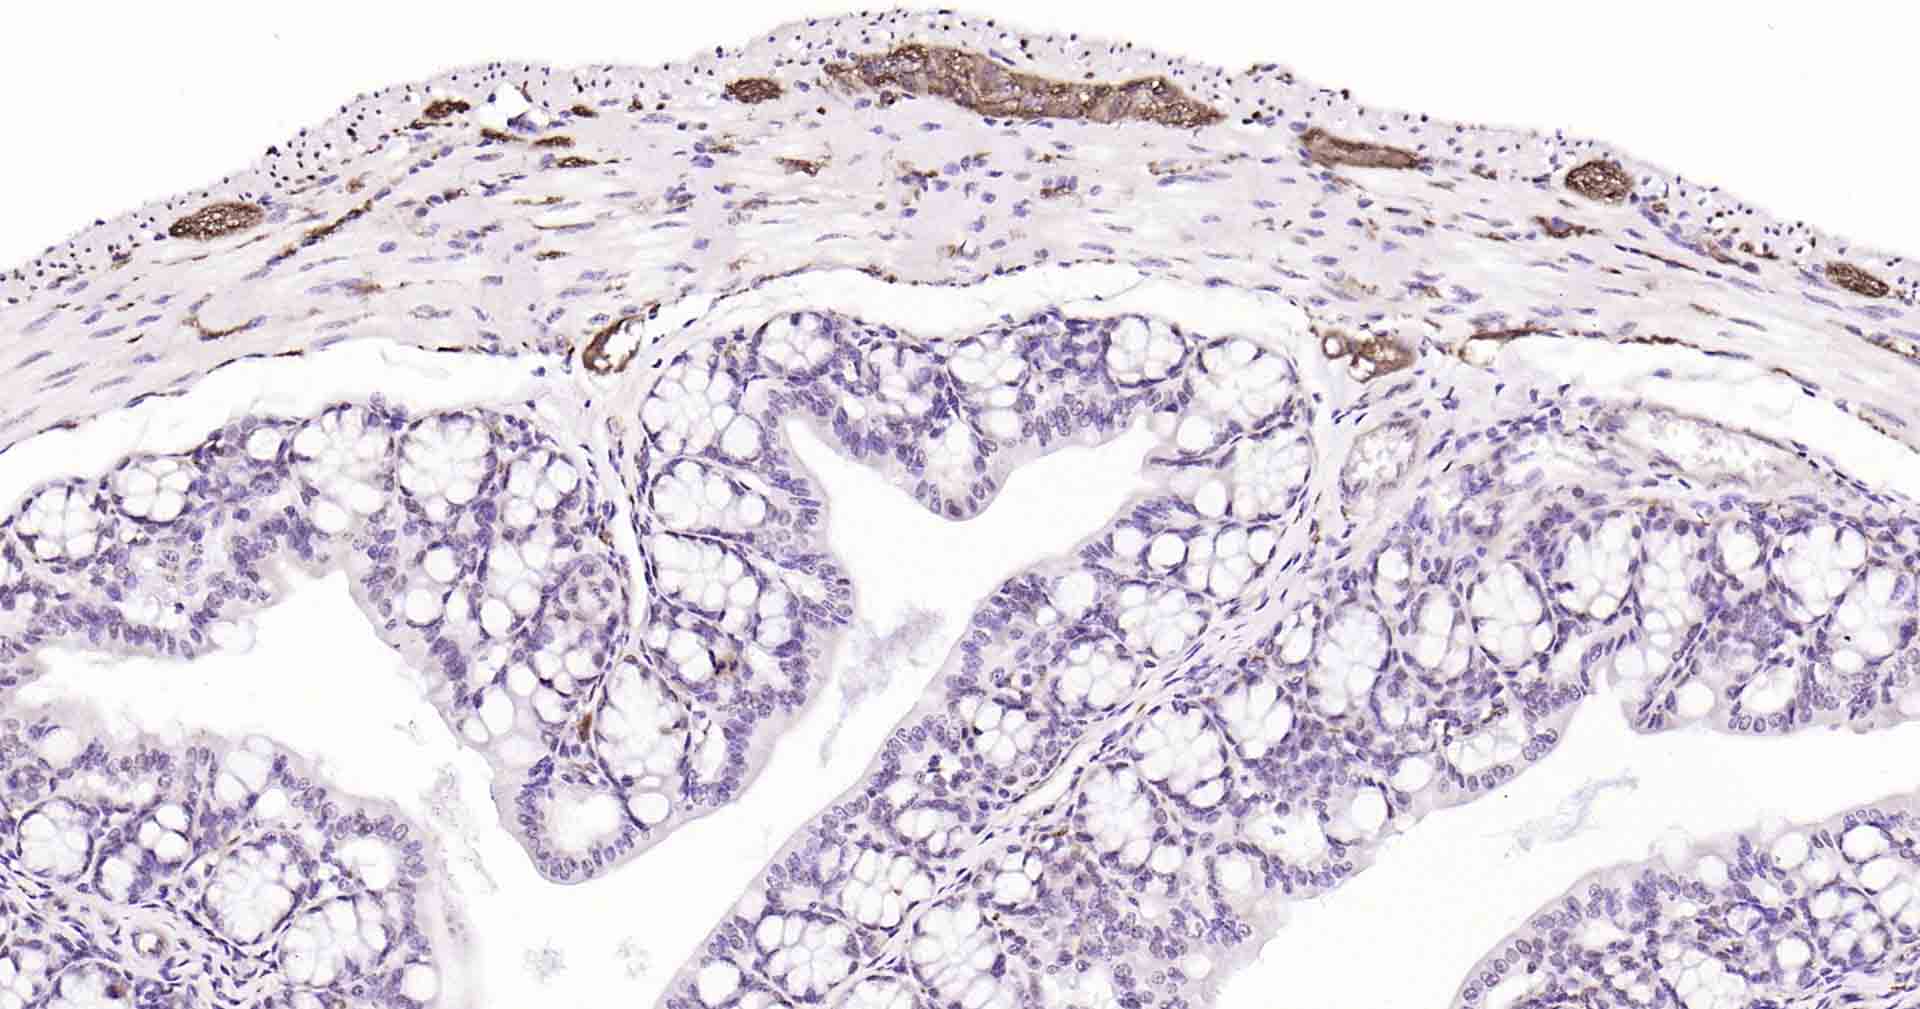
微管相关蛋白重组兔单抗

微管相关蛋白重组兔单抗
Rrmab?兔单抗

货号:bsm-52310R
产品详情
相关标记
相关产品
相关文献
常见问题
概述
产品编号
bsm-52310R
产品类型
重组兔单抗、mIHC精品抗体
英文名称
MAPT/Tau Recombinant Rabbit mAb
中文名称
微管相关蛋白重组兔单抗
英文别名
tau; DDPAC; FTD1; FTDP-17; MAPTL; MSTD; MTBT1; MTBT2; PPND; PPP1R103; Tau-PHF6; tau-40; Mtapt; PHF-tau; MAPT_0N4R; MAPT_1N4R; MAPT_2N4R; RNPTAU; pTau; TAU_BOVIN; MAPT; Neurofibrillary tangle protein; Paired helical filament-tau (PHF-tau); TAU_HUMAN; TAU_MOUSE; TAU_RAT;
抗体来源
Rabbit
免疫原
A synthesized peptide derived from human Tau: 700-740/758
亚型
IgG
性状
Liquid
纯化方法
affinity purified by Protein A
克隆类型
Recombinant
克隆号
1G4
理论分子量
79 kDa
浓度
1mg/ml
储存液
0.01M TBS (pH7.4) with 1% BSA, 0.02% Proclin300 and 50% Glycerol.
研究领域
Neuroscience > Cell Type Marker > Neuron marker > Axon marker
Neuroscience > Neurology process > Neurodegenerative disease
Neuroscience > Neurology process > Neurodegenerative disease > Alzheimer's disease > Tangles & Tau
Signal Transduction > Cytoskeleton / ECM > Cytoskeleton > Microtubules > MT Associated Proteins > Tau
SWISS
Gene ID
保存条件
Shipped at 4℃. Store at -20℃ for one year. Avoid repeated freeze/thaw cycles.
注意事项
This product as supplied is intended for research use only, not for use in human, therapeutic or diagnostic applications.
数据库链接
产品介绍
tau蛋白是脑内神经元细胞支架蛋白之一.其正常功能是促进微管蛋白组成微管,并维持已形成微管的稳定性.参与维持细胞形态、信息传递、细胞分裂等重要生物学过程,是轴突生长发育和神经元极性形成的不可缺少因素.
近年来发现tau蛋白与一些中枢神经系统变性疾病密切相关,尤其是神经Tau具有启动微管系统的装配以及稳定微管系统的作用,该蛋白的错误折叠与老年性痴呆等神经退行性疾病密切相关.
近年来发现tau蛋白与一些中枢神经系统变性疾病密切相关,尤其是神经Tau具有启动微管系统的装配以及稳定微管系统的作用,该蛋白的错误折叠与老年性痴呆等神经退行性疾病密切相关.
背景资料
Tau proteins are important Promotes microtubule assembly and stability, and might be involved in the establishment and maintenance of neuronal polarity. The C-terminus binds axonal microtubules while the N-terminus binds neural plasma membrane components, suggesting that tau functions as a linker protein between both. Axonal polarity is predetermined by tau localization (in the neuronal cell) in the domain of the cell body defined by the centrosome. The short isoforms allow plasticity of the cytoskeleton whereas the longer isoforms may preferentially play a role in its stabilization. Tau proteins subcellular located in the axons of neurons, in the cytoso l and in association with plasma membrane components. It expressed in neurons. PNS-tau is expressed in the peripheral nervous system while the others are expressed in the central nervous system.

产品应用
| 应用 | 已检合格种属 | 预测种属 | 推荐稀释比例 |
|---|---|---|---|
| WB | Mouse, Rat | Human | 1:500-2000 |
| IHC-P | Human, Mouse, Rat | 1:50-200 | |
| IHC-F | Human, Mouse, Rat | 1:50-200 | |
| IF | Human, Mouse, Rat | 1:50-200 |
交叉反应
交叉反应: Human, Mouse, Rat
相关产品
暂无相关产品
靶标
基因名
MAPT
蛋白名
Microtubule-associated protein tau
亚基
Interacts with PSMC2 through SQSTM1. Interacts with SQSTM1 when polyubiquitinated. Interacts with FKBP4. Binds to CSNK1D. Interacts with SGK1.
亚细胞定位
Cytoplasm, cytosol. Cell membrane; Peripheral membrane protein; Cytoplasmic side. Cytoplasm, cytoskeleton. Cell projection, axon. Note=Mostly found in the axons of neurons, in the cytosol and in association with plasma membrane components.
组织特异性
Expressed in neurons. Isoform PNS-tau is expressed in the peripheral nervous system while the others are expressed in the central nervous system.
翻译后修饰
Phosphorylation at serine and threonine residues in S-P or T-P motifs by proline-directed protein kinases (PDPK1: CDK1, CDK5, GSK3, MAPK) (only 2-3 sites per protein in interphase, seven-fold increase in mitosis, and in the form associated with paired helical filaments (PHF-tau)), and at serine residues in K-X-G-S motifs by MAP/microtubule affinity-regulating kinase (MARK1 or MARK2), causing detachment from microtubules, and their disassembly. Phosphorylation decreases with age. Phosphorylation within tau/MAP's repeat domain or in flanking regions seems to reduce tAU/MAP's interaction with, respectively, microtubules or plasma membrane components. Phosphorylation on Ser-610, Ser-622, Ser-641 and Ser-673 in several isoforms during mitosis. Phosphorylation at Ser-548 by GSK3B reduces ability to bind and stabilize microtubules. Phosphorylation at Ser-579 by BRSK1 and BRSK2 in neurons affects ability to bind microtubules and plays a role in neuron polarization. Phosphorylated at Ser-554, Ser-579, Ser-602, Ser-606 and Ser-669 by PHK. Phosphorylation at Ser-214 by SGK1 mediates microtubule depolymerization and neurite formation in hippocampal neurons. There is a reciprocal down-regulation of phosphorylation and O-GlcNAcylation. Phosphorylation on Ser-717 completely abolishes the O-GlcNAcylation on this site, while phosphorylation on Ser-713 and Ser-721 reduces glycosylation by a factor of 2 and 4 respectively. Phosphorylation on Ser-721 is reduced by about 41.5% by GlcNAcylation on Ser-717.
Polyubiquitinated. Requires functional TRAF6 and may provoke SQSTM1-dependent degradation by the proteasome. PHF-tau can be modified by three different forms of polyubiquitination. 'Lys-48'-linked polyubiquitination is the major form, 'Lys-6'-linked and 'Lys-11'-linked polyubiquitination also occur.
O-glycosylated. O-GlcNAcylation content is around 8.2%. There is reciprocal down-regulation of phosphorylation and O-GlcNAcylation. Phosphorylation on Ser-717 completely abolishes the O-GlcNAcylation on this site, while phosphorylation on Ser-713 and Ser-721 reduces O-GlcNAcylation by a factor of 2 and 4 respectively. O-GlcNAcylation on Ser-717 decreases the phosphorylation on Ser-721 by about 41.5%.
Glycation of PHF-tau, but not normal brain TAU/MAPT. Glycation is a non-enzymatic post-translational modification that involves a covalent linkage between a sugar and an amino group of a protein molecule forming ketoamine. Subsequent oxidation, fragmentation and/or cross-linking of ketoamine leads to the production of advanced glycation endproducts (AGES). Glycation may play a role in stabilizing PHF aggregation leading to tangle formation in AD.
Polyubiquitinated. Requires functional TRAF6 and may provoke SQSTM1-dependent degradation by the proteasome. PHF-tau can be modified by three different forms of polyubiquitination. 'Lys-48'-linked polyubiquitination is the major form, 'Lys-6'-linked and 'Lys-11'-linked polyubiquitination also occur.
O-glycosylated. O-GlcNAcylation content is around 8.2%. There is reciprocal down-regulation of phosphorylation and O-GlcNAcylation. Phosphorylation on Ser-717 completely abolishes the O-GlcNAcylation on this site, while phosphorylation on Ser-713 and Ser-721 reduces O-GlcNAcylation by a factor of 2 and 4 respectively. O-GlcNAcylation on Ser-717 decreases the phosphorylation on Ser-721 by about 41.5%.
Glycation of PHF-tau, but not normal brain TAU/MAPT. Glycation is a non-enzymatic post-translational modification that involves a covalent linkage between a sugar and an amino group of a protein molecule forming ketoamine. Subsequent oxidation, fragmentation and/or cross-linking of ketoamine leads to the production of advanced glycation endproducts (AGES). Glycation may play a role in stabilizing PHF aggregation leading to tangle formation in AD.
疾病
Note=In Alzheimer disease, the neuronal cytoskeleton in the brain is progressively disrupted and replaced by tangles of paired helical filaments (PHF) and straight filaments, mainly composed of hyperphosphorylated forms of TAU (PHF-TAU or AD P-TAU). O-GlcNAcylation is greatly reduced in Alzheimer disease brain cerebral cortex leading to an increase in TAU/MAPT phosphorylations.
Defects in MAPT are a cause of frontotemporal dementia (FTD) [MIM:600274]; also called frontotemporal dementia (FTD), pallido-ponto-nigral degeneration (PPND) or historically termed Pick complex. This form of frontotemporal dementia is characterized by presenile dementia with behavioral changes, deterioration of cognitive capacities and loss of memory. In some cases, parkinsonian symptoms are prominent. Neuropathological changes include frontotemporal atrophy often associated with atrophy of the basal ganglia, substantia nigra, amygdala. In most cases, protein tau deposits are found in glial cells and/or neurons.
Defects in MAPT are a cause of Pick disease of the brain (PIDB) [MIM:172700]. It is a rare form of dementia pathologically defined by severe atrophy, neuronal loss and gliosis. It is characterized by the occurrence of tau-positive inclusions, swollen neurons (Pick cells) and argentophilic neuronal inclusions known as Pick bodies that disproportionally affect the frontal and temporal cortical regions. Clinical features include aphasia, apraxia, confusion, anomia, memory loss and personality deterioration.
Note=Defects in MAPT are a cause of corticobasal degeneration (CBD). It is marked by extrapyramidal signs and apraxia and can be associated with memory loss. Neuropathologic features may overlap Alzheimer disease, progressive supranuclear palsy, and Parkinson disease.
Defects in MAPT are a cause of progressive supranuclear palsy type 1 (PSNP1) [MIM:601104]; also abbreviated as PSP and also known as Steele-Richardson-Olszewski syndrome. PSNP1 is characterized by akinetic-rigid syndrome, supranuclear gaze palsy, pyramidal tract dysfunction, pseudobulbar signs and cognitive capacities deterioration. Neurofibrillary tangles and gliosis but no amyloid plaques are found in diseased brains. Most cases appear to be sporadic, with a significant association with a common haplotype including the MAPT gene and the flanking regions. Familial cases show an autosomal dominant pattern of transmission with incomplete penetrance; genetic analysis of a few cases showed the occurrence of tau mutations, including a deletion of Asn-613.
Defects in MAPT are a cause of Parkinson-dementia syndrome (PARDE) [MIM:260540]. A syndrome characterized by parkinsonism tremor, rigidity, dementia, ophthalmoparesis and pyramidal signs. Neurofibrillary degeneration occurs in the hippocampus, basal ganglia and brainstem nuclei.
Defects in MAPT are a cause of frontotemporal dementia (FTD) [MIM:600274]; also called frontotemporal dementia (FTD), pallido-ponto-nigral degeneration (PPND) or historically termed Pick complex. This form of frontotemporal dementia is characterized by presenile dementia with behavioral changes, deterioration of cognitive capacities and loss of memory. In some cases, parkinsonian symptoms are prominent. Neuropathological changes include frontotemporal atrophy often associated with atrophy of the basal ganglia, substantia nigra, amygdala. In most cases, protein tau deposits are found in glial cells and/or neurons.
Defects in MAPT are a cause of Pick disease of the brain (PIDB) [MIM:172700]. It is a rare form of dementia pathologically defined by severe atrophy, neuronal loss and gliosis. It is characterized by the occurrence of tau-positive inclusions, swollen neurons (Pick cells) and argentophilic neuronal inclusions known as Pick bodies that disproportionally affect the frontal and temporal cortical regions. Clinical features include aphasia, apraxia, confusion, anomia, memory loss and personality deterioration.
Note=Defects in MAPT are a cause of corticobasal degeneration (CBD). It is marked by extrapyramidal signs and apraxia and can be associated with memory loss. Neuropathologic features may overlap Alzheimer disease, progressive supranuclear palsy, and Parkinson disease.
Defects in MAPT are a cause of progressive supranuclear palsy type 1 (PSNP1) [MIM:601104]; also abbreviated as PSP and also known as Steele-Richardson-Olszewski syndrome. PSNP1 is characterized by akinetic-rigid syndrome, supranuclear gaze palsy, pyramidal tract dysfunction, pseudobulbar signs and cognitive capacities deterioration. Neurofibrillary tangles and gliosis but no amyloid plaques are found in diseased brains. Most cases appear to be sporadic, with a significant association with a common haplotype including the MAPT gene and the flanking regions. Familial cases show an autosomal dominant pattern of transmission with incomplete penetrance; genetic analysis of a few cases showed the occurrence of tau mutations, including a deletion of Asn-613.
Defects in MAPT are a cause of Parkinson-dementia syndrome (PARDE) [MIM:260540]. A syndrome characterized by parkinsonism tremor, rigidity, dementia, ophthalmoparesis and pyramidal signs. Neurofibrillary degeneration occurs in the hippocampus, basal ganglia and brainstem nuclei.
相似性
Contains 4 Tau/MAP repeats.
功能
Promotes microtubule assembly and stability, and might be involved in the establishment and maintenance of neuronal polarity. The C-terminus binds axonal microtubules while the N-terminus binds neural plasma membrane components, suggesting that tau functions as a linker protein between both. Axonal polarity is predetermined by tau localization (in the neuronal cell) in the domain of the cell body defined by the centrosome. The short isoforms allow plasticity of the cytoskeleton whereas the longer isoforms may preferentially play a role in its stabilization.
标记抗体
暂无标记数据
同靶标产品
暂无同靶标产品
相关文献
提示: 发表研究结果有使用 bsm-52310R 时请让我们知道,以便我们可以引用参考文章。作为回馈,资料提供者将获得我们送上的小礼品。
具体参考文献:bsm-52310R 被引用于13文献中
暂无相关文献
常见问题
暂无常见问题